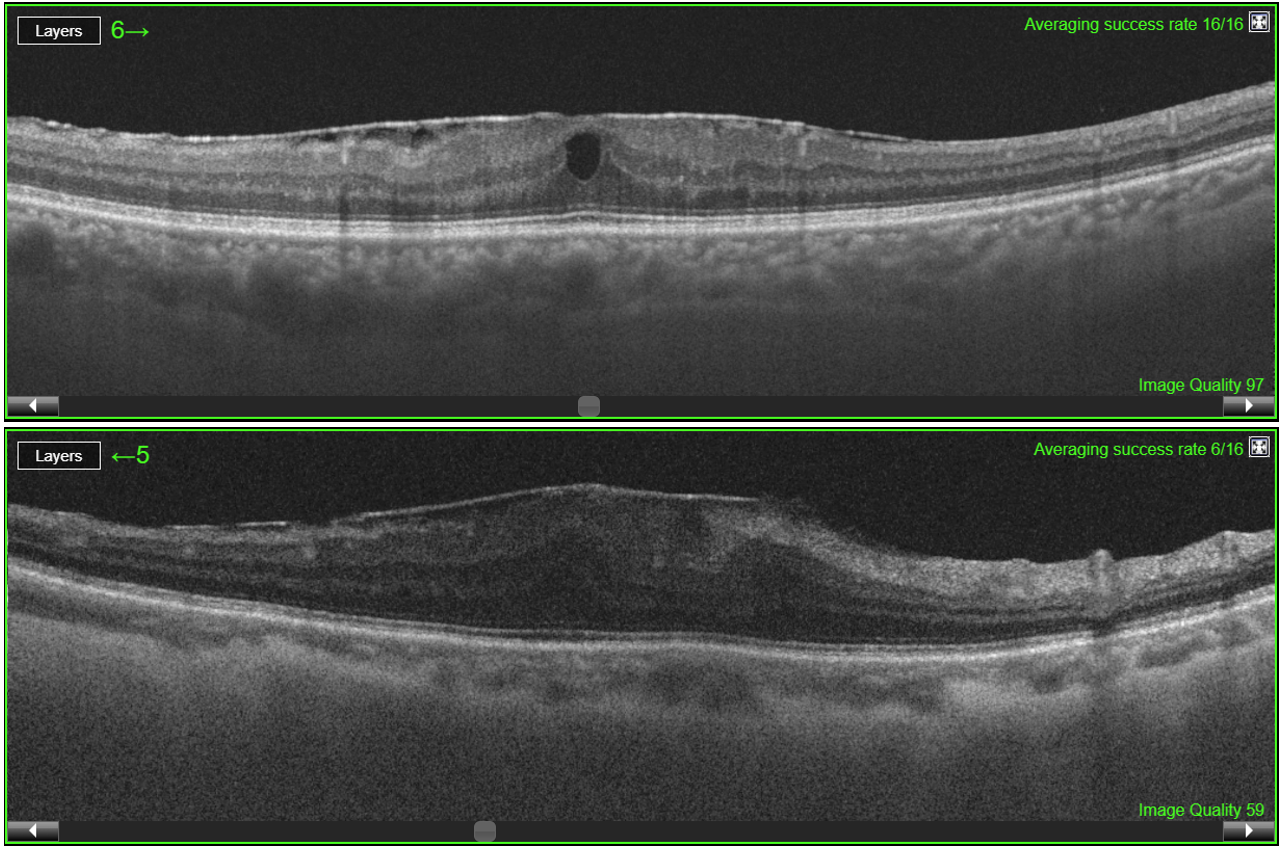

doi: 10.56294/saludcyt2024.1359
ORIGINAL
Assessment of Postoperative Retinal Complications and the Possibility of Optical Diagnostics Using Support Vector Machine
Evaluación de Complicaciones Retinianas Postoperatorias y Posibilidad de Diagnóstico Óptico Mediante Máquina de Vectores de Soporte
Mansur Inkarbekov1,2
![]() ,
Mukhit Kulmaganbetov3,4
,
Mukhit Kulmaganbetov3,4 ![]() *, Galiya Bazarbekova5,6
*, Galiya Bazarbekova5,6
![]() ,
Almagul Baiyrkhanova2,7
,
Almagul Baiyrkhanova2,7 ![]()
1Kazakh-Russian Medical University, Ophthalmology Department. Almaty, Kazakhstan.
2Al-Farabi Kazakh National University, Department of Public Health. Almaty, Kazakhstan.
3Kazakh Eye Research Institute, Glaucoma Department. Almaty, Kazakhstan.
4Centre for Eye and Vision Research (CEVR), Quantum Optics Lab. Hong Kong SAR, PRC.
5Kazakh-Russian Medical University, Department of Oncology with Radiology Course. Almaty, Kazakhstan.
6Asfendiyarov Kazakh National Medical University, Department of Health Policy and Management. Almaty, Kazakhstan.
7Yassawi International Kazakh-Turkish University, Department of Medicine. Turkestan, Kazakhstan.
Cite as: Inkarbekov M, Kulmaganbetov M, Bazarbekova G, Baiyrkhanova A. Assessment of Postoperative Retinal Complications and the Possibility of Optical Diagnostics Using Support Vector Machine. Salud, Ciencia y Tecnología. 2024; 4:.1359. https://doi.org/10.56294/saludcyt2024.1359
Submitted: 09-03-2024 Revised: 17-07-2024 Accepted: 21-11-2024 Published: 22-11-2024
Editor: Prof.
Dr. William Castillo-González ![]()
Corresponding author: Mukhit Kulmaganbetov *
Note: Mansur Inkarbekov and Mukhit Kulmaganbetov are joint first authors
ABSTRACT
Introduction: cataract is a prevalent eye condition that affects millions of individuals worldwide, leading to visual impairment and reduced quality of life. Cataract surgery is the most effective treatment, but post-surgical complications can arise, impacting the success of the intervention. Optical coherence tomography (OCT) has emerged as a valuable imaging technique for evaluating these complications, but the manual interpretation of OCT images is time-consuming and subjective.
Objective: in this study, we aimed to assess the performance of a machine learning (ML) tool specifically developed for detecting post-surgical complications in cataract patients.
Method: we employed a support vector machine (SVM) algorithm to analyze a comprehensive dataset of OCT images. The dataset comprised 700 OCT images obtained post-surgery, including patients with cystoid macular oedema (CMO), retinal detachment (RD), and healthy individuals. The ML tool utilized pre-processed OCT images with annotations provided by expert ophthalmologists, undergoing retinal layer segmentation using intensity-based features.
Results: the SVM algorithm demonstrated high sensitivity and specificity in detecting and classifying post-surgical complications. It achieved a sensitivity of 92,5 % in detecting CMO and 90,9 % in identifying RD. The specificity of the algorithm was 90,9 % and 96,2 % for these complications, respectively. The overall accuracy of the ML tool in correctly identifying and classifying post-surgical complications was 92 %.
Conclusions: the integration of ML algorithms in OCT imaging shows promise in enhancing the accuracy and efficiency of assessing post-surgical complications in cataract patients. The ML tool developed in this study provides reliable and objective assessments, reducing the subjectivity and variability associated with the manual interpretation of OCT images.
Keywords: Cataract; Surgery; Optical Coherence Tomography; Machine Learning; Support Vector Machine.
RESUMEN
Introducción: la catarata es una enfermedad ocular muy común que afecta a millones de personas en todo el mundo y que provoca problemas visuales y una menor calidad de vida. La cirugía de cataratas es el tratamiento más eficaz, pero pueden surgir complicaciones posoperatorias que afecten al éxito de la intervención. La tomografía de coherencia óptica (TCO) ha surgido como una técnica de diagnóstico por imagen valiosa para evaluar estas complicaciones, pero la interpretación manual de las imágenes de TCO requiere mucho tiempo y es subjetiva.
Objetivo: en este estudio, buscamos evaluar el rendimiento de una herramienta de aprendizaje automático (AA) desarrollada específicamente para detectar complicaciones posquirúrgicas en pacientes con cataratas.
Método: utilizamos un algoritmo de máquina de vectores de soporte (MVS) para analizar un conjunto de datos completo de imágenes OCT. El conjunto de datos consistió en 700 imágenes TCO obtenidas después de la cirugía, incluidos pacientes con edema macular cistoide (EMC), desprendimiento de retina (DR) e individuos sanos. La herramienta ML utilizó imágenes TCO preprocesadas con anotaciones proporcionadas por oftalmólogos expertos, sometidas a segmentación de capas de retina utilizando características basadas en la intensidad.
Resultados: el algoritmo MVS demostró una alta sensibilidad y especificidad para detectar y clasificar las complicaciones posquirúrgicas. Logró una sensibilidad del 92,5 % para detectar EMC y del 90,9 % para identificar DR. La especificidad del algoritmo fue del 90,9 % y del 96,2 % para estas complicaciones, respectivamente. La precisión general de la herramienta AA para identificar y clasificar correctamente las complicaciones posquirúrgicas fue del 92 %.
Conclusiones: la integración de algoritmos de aprendizaje automático en las imágenes TCO es prometedora en lo que respecta a la mejora de la precisión y la eficiencia de la evaluación de las complicaciones posquirúrgicas en pacientes con cataratas. La herramienta de aprendizaje automático desarrollada en este estudio proporciona evaluaciones fiables y objetivas, lo que reduce la subjetividad y la variabilidad asociadas a la interpretación manual de las imágenes TCO.
Palabras clave: Cataratas; Cirugía; Tomografía de Coherencia Óptica; Aprendizaje Automático; Máquina de Vectores de Soporte.
INTRODUCTION
Cataract, a prevalent eye condition, affects millions of individuals worldwide, leading to visual impairment and reduced quality of life.(1,2) Cataract surgery has proven to be the most effective treatment, restoring vision and improving patients’ well-being.(3) However, like any surgical procedure, post-surgical complications can arise, impacting the success of the intervention.(4,5)
Optical coherence tomography (OCT) has emerged as a valuable imaging technique for evaluating post-surgical complications in cataract patients.(6,7) OCT provides high-resolution, cross-sectional images of the eye,(8) allowing for detailed assessment of the anterior and posterior segments structures and detection of abnormalities.(9,10) However, the manual interpretation of OCT images can be time-consuming and subjective, relying heavily on the expertise of the interpreting clinician.(11)
To address these limitations, the integration of machine learning (ML) algorithms in OCT imaging holds immense potential.(12,13) ML techniques can analyze large volumes of OCT data, extract relevant features, and learn patterns associated with different post-surgical complications.(14) By leveraging ML, the accuracy and efficiency of interpreting OCT images can be significantly enhanced, leading to more objective and reliable assessments.(15,16)
The primary objective of this study is to assess the performance of an ML tool specifically developed for detecting post-surgical complications in cataract patients. By training the ML model on a comprehensive dataset of OCT images, the tool aims to accurately identify and classify complications such as cystoid macular oedema(17) and retinal detachment.(18) The ultimate goal is to provide clinicians with a reliable, automated tool that can aid in the early detection and management of post-surgical complications, leading to improved patient care and favorable outcomes.
By evaluating the performance of the ML tool in this study, we aim to contribute to the growing body of research exploring the potential of ML in enhancing ophthalmic diagnostics and interventions. The findings of this study have the potential to revolutionize cataract care, offering a promising solution for better patient outcomes, reduced healthcare costs, and improved overall quality of life for individuals affected by cataract surgery. The general objective of this study is to assess the performance of a machine learning tool specifically developed for detecting postoperative complications in cataract patients.
METHOD
Participants
The study design employed a retrospective approach, utilizing data collected from the medical records of patients who underwent cataract surgery. All participants in the study underwent standard cataract surgery, which involved phacoemulsification with intraocular lens (IOL) implantation. The surgical procedures were performed by experienced ophthalmic surgeons following established protocols.
This retrospective study utilized a sample of patients who underwent cataract surgery at State City Clinic No. 13 between January 2021 and December 2024. The inclusion criteria comprised patients who had available OCT imaging records post-surgery. A total of 700 participants were included in the study.
The study received approval from the Local Ethical Committee of the Al-Farabi Kazakh National University and adhered to the principles outlined in the Declaration of Helsinki. Patient consent was waived for this retrospective analysis as the data was anonymized and did not involve any direct patient contact.
Optical coherence tomography imaging
OCT images were obtained using Topcon DRI OCT Triton (Japan), a widely used and commercially available device known for its high-resolution imaging capabilities. The OCT scans were performed within a specified time frame post-surgery, typically between 7-14 days after the phacoemulsification to ensure consistency and relevance to post-surgical complications.
Machine learning and data analysis
In this study, a support vector machine (SVM) algorithm was employed for the detection and classification of post-surgical complications. Pre-processed OCT images with annotations provided by expert ophthalmologists, underwent retinal layer segmentation using the intensity-based features. These features capture the variation in pixel intensity values within the image. We included mean intensity, standard deviation, and histogram-based features (intensity distribution or texture features).(15)
The algorithm was developed and implemented using the high-level programming language Python, version 3.12 (Python Software Foundation, US), taking into account relevant features and patterns associated with each complication.
The collected OCT images were processed using the SVM, which classified the images into two categories of post-surgical complications. The performance of the ML tool in detecting complications was evaluated based on various metrics such as sensitivity (1), specificity (2), and accuracy (3). Statistical analysis was conducted to assess the significance of the results and determine the overall performance of the SVM algorithm.
· Sensitivity (TPR)=(True Positives)/(True Positives + False Negatives)×100 (1)
· Specificity (TNR)=(True Negatives)/(True Negatives + False Positives)×100 (2)
· Accuracy=(True Positives + True Negatives)/(True Positives + True Negatives + False Positives + False Negatives)×100 (3)
Where TPR is a true positive rate and TNR is a true negative rate.
RESULTS
Among 700 patients, 438 patients who underwent cataract surgery had cystoid macular oedema (NCMO=274) or retinal detachment (NRD=164), and NH=262 patients did not have any retinal diseases/complications. The dataset consisted of 700 OCT B-scan macular images obtained post-surgery (figure 1), 80 % of them were randomly selected for the training of SVM, whereas 20 % of the data were used to test the algorithm (table 1).
|
Table 1. OCT image dataset for the support vector machine |
|||
|
Condition |
Total dataset |
Training dataset (80 %) |
Test dataset (20 %) |
|
Cystoid macular oedema |
274 |
219 |
55 |
|
Retinal detachment |
164 |
131 |
33 |
|
Healthy |
262 |
210 |
52 |
|
Total |
700 |
560 |
140 |
The SVM algorithm detected and classified two post-surgical complications based on the OCT images. The overall performance of the ML tool in detecting complications was evaluated using different metrics, including sensitivity, specificity, and accuracy (table 2).
The results showed that the SVM achieved a sensitivity of 92,5 % in detecting cystoid macular oedema, and 90,9 % in identifying retinal detachment. The specificity of the algorithm was 90,9 % and 96,2 %, respectively, for these complications. These findings suggest that the ML tool can effectively assist in the early detection and classification of retina-related common complications following cataract surgery.
Figure 1. OCT B-scans of cystoid macular oedema (top) and retinal detachment (bottom) after cataract surgery
|
Table 2. Sensitivity, specificity, and accuracy of the support vector machine in detecting post-surgical complications |
|||
|
Metrics |
Complications |
||
|
Cystoid macular oedema |
Retinal detachment |
Overall |
|
|
Sensitivity |
92,5 % |
90,9 % |
93,3 % |
|
Specificity |
90,9 % |
96,2 % |
89,6 % |
|
Accuracy |
91,7 % |
94,1 % |
92 % |
Furthermore, the ML algorithm demonstrated a high overall accuracy of 92 % (Sensitivity ≈ 93,3 % and Specificity ≈ 89,6 %) in correctly identifying and classifying post-surgical complications (figure 2). This indicates the potential of ML in providing reliable and objective assessments, reducing the subjectivity and variability associated with the manual interpretation of OCT images.
It is important to note that while the ML algorithm showed promising results, there were certain limitations. The performance of the algorithm may be influenced by the quality and variability of the OCT images, as well as the specific characteristics of the dataset used for training. Additionally, the generalizability of the findings to a larger population should be considered.
Overall, the results of this study support the potential of machine learning in enhancing the detection and management of post-surgical complications in cataract patients. The use of ML algorithms in OCT imaging can contribute to improved patient care, more efficient diagnosis, and better outcomes in the field of ophthalmology. Further research and validation studies are warranted to optimize and refine the ML tool for broader clinical applications.

Figure 2. The area under the receiver operating characteristic (ROC) curve (AUC) of the support vector machine in classifying post-surgical complications, including cystoid macular oedema and retinal detachment
DISCUSSION
The present study aimed to assess the performance of a machine learning algorithm in detecting and classifying post-surgical complications following cataract surgery using OCT imaging. The results demonstrated that the SVM achieved significant success in identifying complications such as cystoid macular oedema, and retinal detachment.
The integration of ML in OCT imaging offers several advantages over traditional manual interpretation. The SVM algorithm showed high sensitivity, specificity, and accuracy in detecting complications, reducing the subjectivity and variability associated with human interpretation. This suggests that the ML tool can serve as a reliable and objective aid in the early detection and management of post-surgical complications.
The findings of this study align with previous research highlighting the potential of ML in ophthalmology.(19,20,21,22) ML algorithms can efficiently analyze large volumes of OCT data, extract relevant features, and learn patterns associated with different complications.(23,2,42) Scheer and Marcus-Freeman (2019) utilized OCT to detect and assess wound leaks or gaps following cataract surgery.(25) The prompt identification and treatment of these postoperative complications are crucial for achieving optimal outcomes in patients undergoing cataract surgery. By using OCT, clinicians are empowered to make well-informed decisions and provide timely interventions, ultimately resulting in improved patient outcomes.
It is crucial to acknowledge the limitations of this study. The retrospective nature of the data collection may introduce selection bias and limit the generalizability of the findings to a larger population. Additionally, the performance of the ML algorithm may be influenced by the quality and variability of the OCT images used for training.(26) Future studies should aim to address these limitations by conducting prospective research with diverse patient populations and standardized imaging protocols.
The successful implementation of ML in OCT imaging has significant implications for clinical practice. The ML tool can assist clinicians in triaging patients, prioritizing those at higher risk of complications, and allocating resources accordingly. Additionally, the automated analysis provided by the ML algorithm can save time and effort for clinicians, allowing them to focus on more complex cases and personalized patient care.
Furthermore, the ML tool has the potential to improve access to quality healthcare, especially in resource-limited settings. By automating the detection and classification of complications, the ML algorithm can bridge the gap between ophthalmic expertise and areas with limited access to specialized care. This can lead to earlier interventions, reduced healthcare costs, and improved patient outcomes in diverse healthcare settings.
While the results of this study are promising, further research is needed to optimize and refine the ML algorithm. The algorithm’s performance can be enhanced by incorporating larger and more diverse datasets, including longitudinal data to assess changes over time. Additionally, ongoing collaboration between ophthalmologists, data scientists, and engineers is crucial for improving and validating the ML tool.
CONCLUSIONS
The integration of ML algorithms in OCT imaging offers a promising solution for the detection and classification of post-surgical complications following cataract surgery. The findings of this study underscore the potential of ML in improving patient care, enhancing diagnostic accuracy, and advancing the field of ophthalmology. Continued research and advancements in ML technology are promising to revolutionize the management of cataract surgery and other ophthalmic interventions.
REFERENCES
1. Song P, Wang H, Theodoratou E, Chan KY, Rudan I. The national and subnational prevalence of cataract and cataract blindness in China: a systematic review and meta-analysis. Journal of Global Health. 2018;8(1):010804. https://doi.org/10.7189/jogh.08.010804
2. Cicinelli MV, Buchan JC, Nicholson M, Varadaraj V, Khanna RC. Cataracts. Lancet. 2023;401(10374):377-389. https://doi.org/10.1016/S0140-6736(22)01839-6
3. Polack S. Restoring sight: how cataract surgery improves the lives of older adults. Community Eye Health. 2008;21(66):24–25.
4. Stein JD. Serious adverse events after cataract surgery. Current Opinion in Ophthalmology. 2012;23(3):219–225. https://doi.org/10.1097/ICU.0b013e3283524068
5. Yong GY, Mohamed-Noor J, Salowi MA, Adnan TH, Zahari M. Risk factors affecting cataract surgery outcome: The Malaysian cataract surgery registry. PloS one. 2022;17(9):e0274939. https://doi.org/10.1371/journal.pone.0274939
6. Vukicevic M, Gin T, Al-Qureshi S. Prevalence of optical coherence tomography-diagnosed postoperative cystoid macular oedema in patients following uncomplicated phacoemulsification cataract surgery. Clinical & Experimental Ophthalmology. 2012;40(3):282-287. https://doi.org/10.1111/j.1442-9071.2011.02638.x
7. Nguyen P, Chopra V. Applications of optical coherence tomography in cataract surgery. Current Opinion in Ophthalmology. 2013 Jan;24(1):47-52. https://doi.org/10.1097/ICU.0b013e32835aee7b
8. Fujimoto JG, Pitris C, Boppart SA, Brezinski ME. Optical coherence tomography: an emerging technology for biomedical imaging and optical biopsy. Neoplasia (New York, N.Y.). 2000;2(1-2):9–25. https://doi.org/10.1038/sj.neo.7900071
9. Ang M, Baskaran M, Werkmeister RM, Chua J, Schmidl D, dos Santos VA, et al. Anterior segment optical coherence tomography. Progress in Retinal and Eye Research. 2018;66:132-156. https://doi.org/10.1016/j.preteyeres.2018.04.002
10. Zeppieri M, Marsili S, Enaholo ES, Shuaibu AO, Uwagboe N, Salati C, et al. Optical Coherence Tomography (OCT): A Brief Look at the Uses and Technological Evolution of Ophthalmology. Medicina. 2023;59:2114. https://doi.org/10.3390/medicina59122114
11. Karn PK, Abdulla WH. On Machine Learning in Clinical Interpretation of Retinal Diseases Using OCT Images. Bioengineering (Basel, Switzerland). 2023;10(4):407. https://doi.org/10.3390/bioengineering10040407
12. Balyen L, Peto T. Promising Artificial Intelligence-Machine Learning-Deep Learning Algorithms in Ophthalmology. Asia-Pacific Journal of Ophthalmology. 2019;8(3):264-272. https://doi.org/10.22608/APO.2018479
13. Yang D, Ran AR, Nguyen TX, Lin TPH, Chen H, Lai TYY, et al. Deep Learning in Optical Coherence Tomography Angiography: Current Progress, Challenges, and Future Directions. Diagnostics. 2023;13(2):326. https://doi.org/10.3390/diagnostics13020326
14. Li M, Jiang Y, Zhang Y, Zhu H. Medical image analysis using deep learning algorithms. Frontiers in Public Health. 2023;11:1273253. https://doi.org/10.3389/fpubh.2023.1273253
15. Kulmaganbetov M, Bevan RJ, Anantrasirichai N, Achim A, Erchova I, White N, et al. Textural Feature Analysis of Optical Coherence Tomography Phantoms. Electronics. 2022;11(4):669. https://doi.org/10.3390/electronics11040669
16. Riazi Esfahani P, Reddy AJ, Nawathey N, Ghauri MS, Min M, Wagh H, et al. Deep Learning Classification of Drusen, Choroidal Neovascularization, and Diabetic Macular Edema in Optical Coherence Tomography (OCT) Images. Cureus. 2023;15(7):e41615. https://doi.org/10.7759/cureus.41615
17. Chu CJ, Johnston RL, Buscombe C, Sallam AB, Mohamed Q, Yang YC, et al. Risk Factors and Incidence of Macular Edema after Cataract Surgery: A Database Study of 81984 Eyes. Ophthalmology. 2016;123(2):316-323. https://doi.org/10.1016/j.ophtha.2015.10.001
18. Olsen T, Jeppesen P. The incidence of retinal detachment after cataract surgery. The Open Ophthalmology Journal. 2012;6:79–82. https://doi.org/10.2174/1874364101206010079
19. Kyrykbayev D, Amanzhanovna Oteulieva M, Mukhamedzhanovna Auezova A, Kairatovna Zhurgumbayeva G. Improving Organizational Medical Care for Patients with Idiopathic Macular Hole: Impact on Quality of Life and Effectiveness of Modern Treatment Protocols. Salud, Ciencia y Tecnología. 2024;4:1315.
20. Radha R, Radha N, Swathika R, Poongavanam N, Mishmala S. Time Series Analysis of Clinical Dataset Using ImageNet Classifier. Salud, Ciencia y Tecnología. 2024;4:837.
21. Moraru AD, Costin D, Moraru RL, Branisteanu DC. Artificial intelligence and deep learning in ophthalmology - present and future (Review). Experimental and Therapeutic Medicine. 2020;20:3469-3473. https://doi.org/10.3892/etm.2020.9118
22. Srivastava O, Tennant M, Grewal P, Rubin U, Seamone M. Artificial intelligence and machine learning in ophthalmology: A review. Indian Journal of Ophthalmology. 2023;71(1):11–17. https://doi.org/10.4103/ijo.IJO_1569_22
23. Yanagihara RT, Lee CS, Ting DSW, Lee AY. Methodological Challenges of Deep Learning in Optical Coherence Tomography for Retinal Diseases: A Review. Translational Vision Science and Technology. 2020;9(2):11. https://doi.org/10.1167/tvst.9.2.11
24. Sarker IH. Machine Learning: Algorithms, Real-World Applications and Research Directions. SN Computer Science. 2021;2(3):160. https://doi.org/10.1007/s42979-021-00592-x
25. Scheer L, Marcus-Freeman S. Using Optical Coherence Tomography in the Management of Postoperative Wound Leaks After Cataract Surgery. Federal practitioner: for the health care professionals of the VA, DoD, and PHS. 2019;36(8):356–364.
26. Romo-Bucheli D, Seeböck P, Orlando JI, Gerendas BS, Waldstein SM, Schmidt-Erfurth U, et al. Reducing image variability across OCT devices with unsupervised unpaired learning for improved segmentation of retina. Biomedical Optics Express. 2019;11(1):346–363. https://doi.org/10.1364/BOE.379978
FINANCING
The authors did not receive financing for the development of this research. M.K. was supported by the InnoHK initiative and the Hong Kong Special Administrative Region Government.
CONFLICT OF INTEREST
The authors declare that there is no conflict of interest.
AUTHORSHIP CONTRIBUTION
Conceptualization: Mansur Inkarbekov, Mukhit Kulmaganbetov.
Data curation: Galiya Bazarbekova.
Formal analysis: Mukhit Kulmaganbetov.
Research: Galiya Bazarbekova.
Methodology: Mansur Inkarbekov.
Project management: Almagul Baiyrkhanova.
Resources: Galiya Bazarbekova.
Software: Mukhit Kulmaganbetov.
Supervision: Mukhit Kulmaganbetov.
Validation: Almagul Baiyrkhanova.
Display: Almagul Baiyrkhanova.
Drafting - original draft: Mansur Inkarbekov, Mukhit Kulmaganbetov.
Writing - proofreading and editing: Galiya Bazarbekova, Almagul Baiyrkhanova.